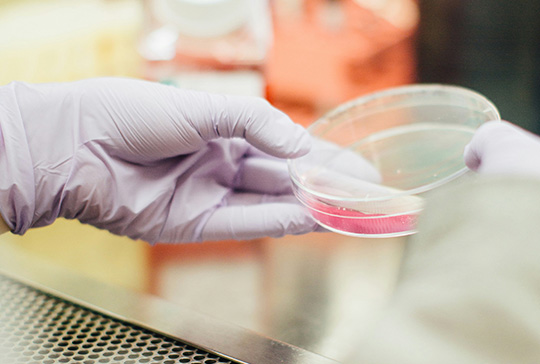

[글로벌 세미나/전시] IMTS 2024: 글로벌 제조 혁신의 무대에서 미래를 준비하세요

IMTS 2024에서 글로벌 제조 시장 진출을 위한 전략적 기회를 모색하세요. IMTS 2024가 2024년 9월 9일부터 14일까지 미국 시카고에서 열립니다. 2년마다 개최되는 이 행사는 글로벌 제조업계의 최신 기술과 혁신을 한 자리에서 만날 수 있는 기회입니다. 자세한 행사 정보: https://www.imts.com/ IMTS 2024: 글로벌 제조업의 혁신 허브 IMTS 2024는 전 세계 제조업계의 주요 기업들과 […]
[글로벌 세미나/전시] K뷰티 엑스포 2024: 글로벌 뷰티 산업의 미래를 이끌 트렌드를 만나보세요!

K-BEAUTY EXPO KOREA 2024 K Beauty Expo 2024는 뷰티 산업의 최신 트렌드를 한눈에 볼 수 있는 행사로, 킨텍스에서 10월 17일부터 20일까지 개최됩니다. 이번 엑스포는 K-뷰티의 세계적인 위상을 다시 한번 확인할 수 있는 자리로, 글로벌 뷰티 업계의 혁신 제품과 기술들을 직접 경험할 수 있습니다. 자세한 행사 정보: https://k-beautyexpo.co.kr/ ‘K-뷰티 엑스포’ 란? K-뷰티 […]
[글로벌 세미나/전시] NRF Retail Big Show 2025: 글로벌 리테일 트렌드와 혁신 기술을 한눈에!

NRF Retail Big Show 2025 NRF Retail Big Show 2025가 1월 13일부터 15일까지 뉴욕에서 개최됩니다. 리테일 업계의 최신 트렌드와 혁신 기술을 한자리에서 만나볼 수 있는 이번 행사에 참여하여 글로벌 시장 진출을 모색해 보세요. 자세한 행사 정보: https://nrfbigshow.nrf.com/ NRF Retail Big Show란? NRF Retail Big Show는 세계 최대의 리테일 컨퍼런스입니다. 매년 1월, 전 […]
IoT 반도체 시장조사 보고서 발간 -2031년까지 410억 달러연평균 성장률(CAGR) 8.5%

최신 데타에이아이 시장 조사 보고서에 따르면, 글로벌 IoT(사물인터넷) 반도체 시장 규모는 2031년까지 410억 달러에 도달할 것으로 예상되며, 2024년부터 2031년까지 연평균 성장률(CAGR) 8.5%를 기록할 것으로 보인다. 주요 성장 동력 및 시장 인사이트 ▶ 프로세서 부문 최고 성장: 고성능 저전력 프로세서에 대한 수요 증가, IoT 및 AI 기술의 채택 확대, 고급 보안 기능 필요성이 프로세서 부문의 […]
[글로벌 세미나/전시] 인도 시장 진출, KoINDEX 2024로 시작하세요!

인도 최초 뉴델리 대한민국 산업전시회 KoINDEX 2024가 오는 11월 21일부터 23일까지 인도 뉴델리의 Yashobhoomi에서 열립니다. 이 행사는 남아시아를 넘어 중동과 아프리카 시장까지 겨냥하며, 건설, HVAC, 스마트 시티 기술, 헬스테크, 식품 가공, 뷰티 등 다양한 산업을 위한 비즈니스 플랫폼을 제공합니다. 이미지 출처: https://koindex.kr/ 왜 인도인가? 인도는 14억 인구와 세계 5위의 GDP를 자랑하는 빠르게 성장하는 […]
바이오 제약 산업 전망 보고서 발간: 글로벌 시장 동향과 성장 기회
바이오제약 산업의 글로벌 시장 확장과 주요 기술 트렌드를 담은 최신 맞춤형 보고서가 발간되었다. 데타에이아이컨설팅코리아가 발행한 이번 보고서는 바이오제약 산업의 글로벌 시장 동향, 국가별 수출 동향, 성공 사례, 데이터와 통계를 활용한 시장 전망 등을 다루고 있으며, 신사업 및 신제품 기획을 통해 글로벌 시장에 진출하고자 하는 기업들에게 유용한 정보를 제공한다. 보고서에 따르면, 바이오제약 시장 규모는 2030년까지 […]
인공지능(AI) 글로벌 시장 전망 보고서 발간

인공지능(AI) 산업의 글로벌 시장 확장과 주요 기술 트렌드를 담은 최신 보고서가 발간되었다. 데타에이아이컨설팅코리아는 기업들이 글로벌 시장에서 성공적으로 진출할 수 있도록 다양한 산업에서의 인사이트와 맞춤형 보고서를 제공한다. 이번 보고서에서는 인공지능 산업의 글로벌 시장 동향, 국가별 수출 전략, 성공 사례, 데이터와 통계를 활용한 시장 전망 등을 다루고 있다. 보고서에 따르면 인공지능 시장은 2030년까지 1조 350억 달러에 이를 […]
특허/인증 5
내용이 나오는 것입니다. 무엇이든 내용을 입력하면 됩니다. 내용이 나오는 것입니다. 무엇이든 내용을 입력하면 됩니다. 내용이 나오는 것입니다. 무엇이든 내용을 입력하면 됩니다.
특허/인증 4
내용이 나오는 것입니다. 무엇이든 내용을 입력하면 됩니다. 내용이 나오는 것입니다. 무엇이든 내용을 입력하면 됩니다. 내용이 나오는 것입니다. 무엇이든 내용을 입력하면 됩니다.
특허/인증 6
내용이 나오는 것입니다. 무엇이든 내용을 입력하면 됩니다. 내용이 나오는 것입니다. 무엇이든 내용을 입력하면 됩니다. 내용이 나오는 것입니다. 무엇이든 내용을 입력하면 됩니다.
특허/인증 3
내용이 나오는 것입니다. 무엇이든 내용을 입력하면 됩니다. 내용이 나오는 것입니다. 무엇이든 내용을 입력하면 됩니다. 내용이 나오는 것입니다. 무엇이든 내용을 입력하면 됩니다.
특허/인증 1
내용이 나오는 것입니다. 무엇이든 내용을 입력하면 됩니다. 내용이 나오는 것입니다. 무엇이든 내용을 입력하면 됩니다. 내용이 나오는 것입니다. 무엇이든 내용을 입력하면 됩니다.